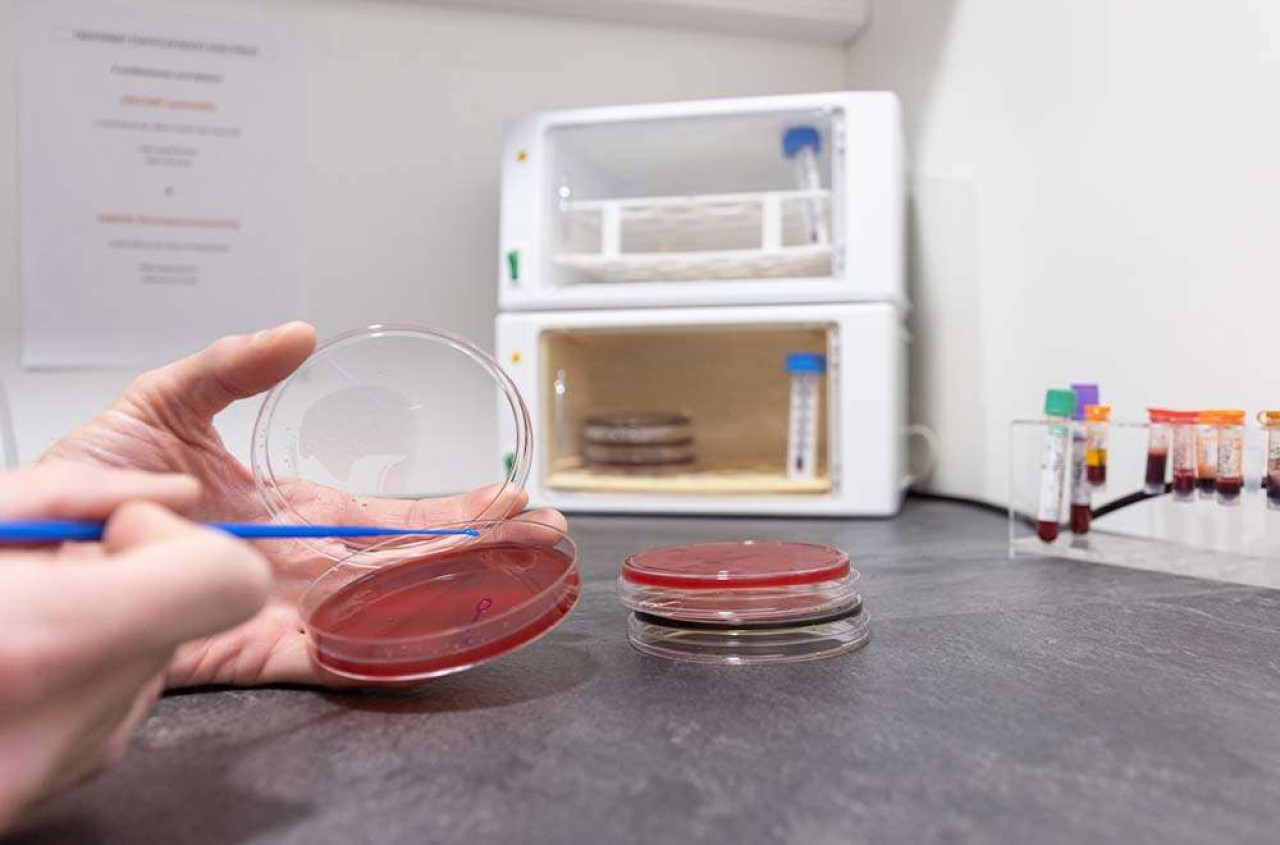

Vétérinaire mixte à dominante canine 7 sem de CP - 4 j par sem (F/H)
A propos de nous
A 1 heure de route de Lyon, la clientèle est basée dans le JURA (39) autour de Saint Amour à quelques kms de l'AIN (01) et de la SAONE-ET-LOIRE (71). La zone est très bien desservie en transports avec une autoroute (A39), une route nationale (RN83) et une gare SNCF à Saint Amour. Le relief est composé d'une plaine coté Bresse et de petite montagne coté Revermont. De nombreux logements en location sont disponibles à Saint Amour et dans la région. Activité canine de qualité: échocardiographie - médecine interne- laboratoire complet
Activité rurale laitière de qualité (zone comté)
Description du poste
Vétérinaire mixte a dominante canine cadre autonome avec gardes (formation obstétrique assurée si débutant).
4 j par semaine de travail, 7 semaines de congés par an, clinique fermée samedi après-midi.
Clinique indépendante située aux portes de la petite montagne dans le Jura. Région touristique proche du pays des lacs à 1 h de Lyon et 30 minutes de Bourg en Bresse et Lons le Saunier.
Structure à activité mixte à dominante canine.
Équipe jeune et dynamique avec très bonne ambiance dans la structure. Travail en équipe. Partage des cas. Structure à taille humaine où chacun peut trouver sa place.
Activité canine de qualité avec plateau technique performant: radio numérique capteur plan, échographie doppler, échocardiographie avec formation possible, dentisterie avec radio dentaire et unité dentaire, laboratoire complet, pompes à perfusion etc...
Activité rurale laitière en AOC Comté en pleine dynamique: Suivi repro, bactériologie de lait, compteur cellulaire, analyses sanguines...
Véhicule fourni
Poste disponible dès Décembre
www.veterinaires-des-portes-du-jura.fr
Profil recherché
Activité mixte avec prédominance canine. Toutes durées d'expérience acceptées, formation assurée quel que soit le domaine : obstétrique, médecine, repro pour la partie rurale et pour la partie canine : médecine interne, imagerie (échographie abdominale, échocardiographie, radiographie), dentisterie, chirurgie ….
Désireux de travailler en équipe et de rejoindre une structure en pleine dynamique.
En images
Conditions
- Pour commencer : dès Décembre 2025
- Astreinte : oui - 1 garde par semaine et un week end toutes les 5 à 6 semaines
- Rémunération : Convention collective majorée + 2 semaines de congés offertes !
- Temps complet
-
Avantages :
- Voiture


-(1)-optimized.jpg)

-(1)-optimized.jpg)